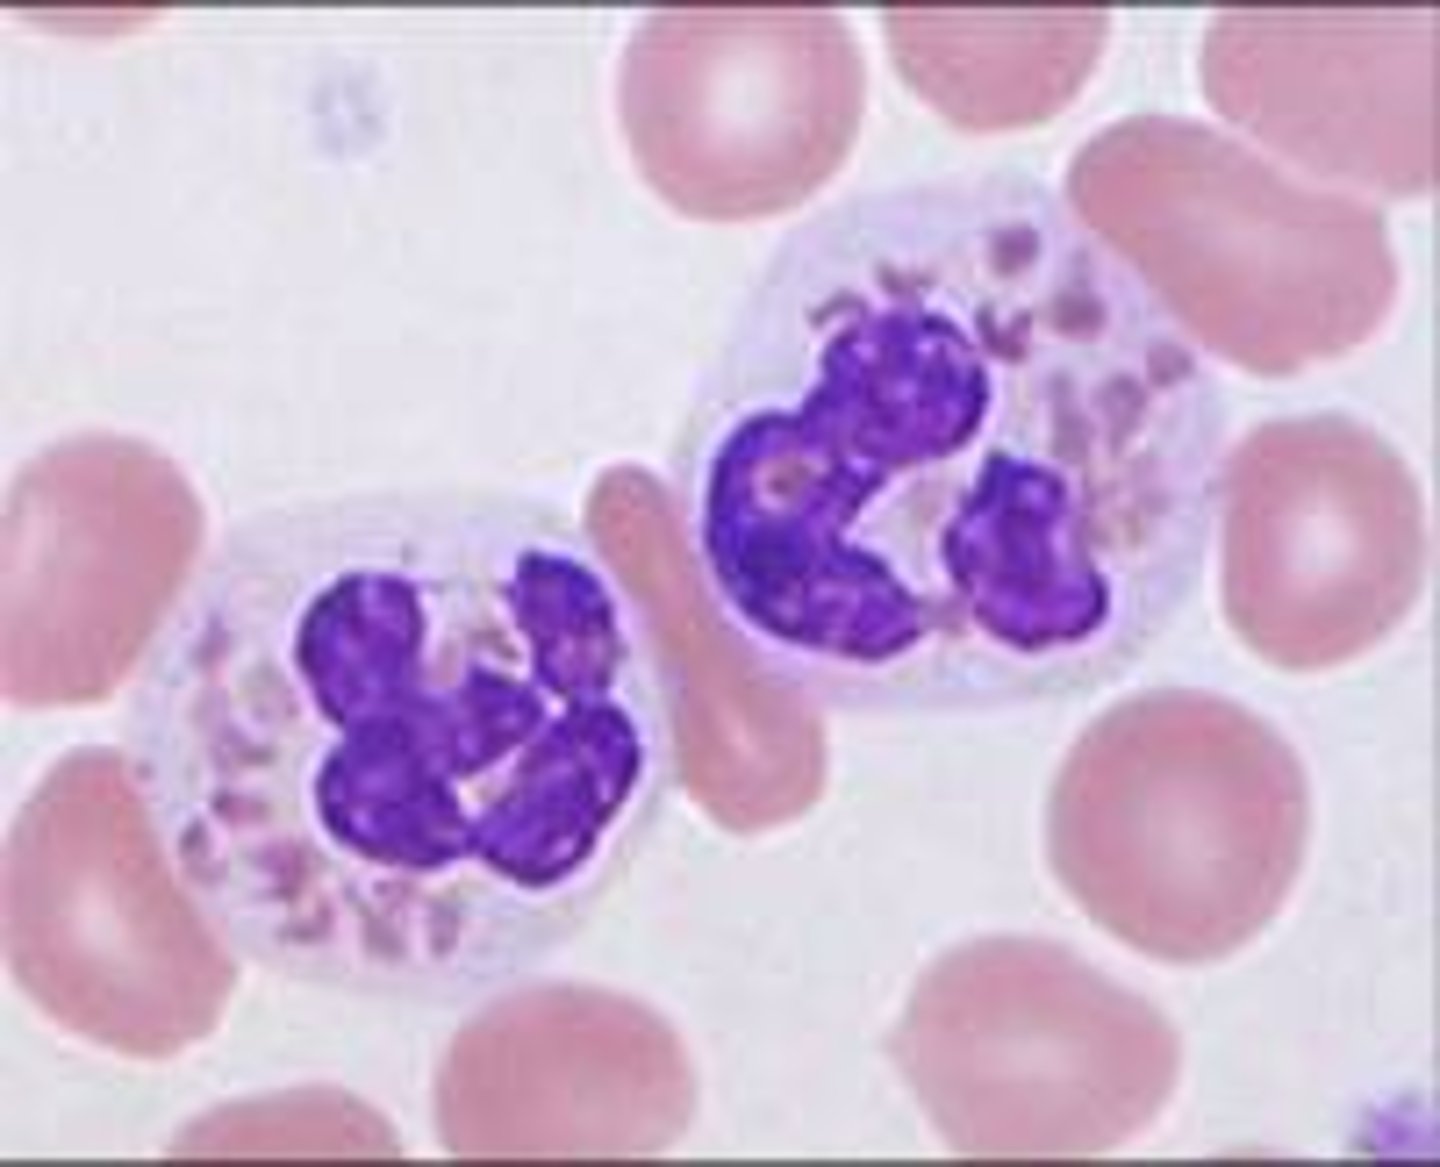

1/72
Looks like no tags are added yet.
Name | Mastery | Learn | Test | Matching | Spaced | Call with Kai |
|---|
No analytics yet
Send a link to your students to track their progress
Target cells (codocytes)

Teardrop cell (dacryocytes)

Sickle cells (drepanocytes)

Elliptocytes (ovalocytes)

Spherocytes

Stomatocytes

Schistocytes

Acanthocytes (spur cells)

Echinocytes (Burr cell)

Basophilic stippling

howell-jolly bodies

pappenheimer bodies

Hemoglobin C crystals

cabot rings

Heinz bodies

malaria

babesia

toxic granulation

toxic vacuoles

dohle bodies

monolobate

pyknotic cell

May-Hegglin Anomaly

Pelger-Huet/Prince nez anomaly

Hypersegmented neutrophils

Auer rod

plasma cell

segmented neutrophil

band neutrophil

resting lymph

reactive lymph

basophil

eosinophil

monocyte

myeloblast

promyelocyte

myelocyte

metamyelocyte

Pronormoblast (Rubriblast)

Basophilic Normomoblast (Prorubricyte)

Polychromatophilic Normoblast (Rubricyte)

Orthochromic Normoblast (Metarubricyte)

Polychromatophilic Erythrocyte

Reticulocyte

Erythrocyte (Mature RBC)

Macrocytic RBC

Microcytic RBC

NRBC

Hypochromic RBC

Anisocytosis

Poikilocytosis

rouleaux

RBC agglutination

platelet

giant platelets

platelet clumps

platelet satellitism

Hypogranular neutrophil

large granular lymphocyte

smudge cell

Crenated RBC

stain precipitate

Hairy Cells

Sezary Cell

Dutcher bodies

megakaryocyte

Ringed Sideroblast

Alder-Reilly Anomaly

Chediak-Higashi syndrome
Gaucher cell

Niemann-Pick cell

F@ggot cells

Reed Sternberg cell
